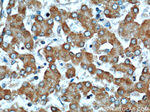
LRDD Antibody in Immunohistochemistry (Paraffin) (IHC (P))

Search
Proteintech
LRDD Polyclonal Antibody
{{$productOrderCtrl.translations['antibody.pdp.commerceCard.promotion.promotions']}}
{{$productOrderCtrl.translations['antibody.pdp.commerceCard.promotion.viewpromo']}}
{{$productOrderCtrl.translations['antibody.pdp.commerceCard.promotion.promocode']}}: {{promo.promoCode}} {{promo.promoTitle}} {{promo.promoDescription}}. {{$productOrderCtrl.translations['antibody.pdp.commerceCard.promotion.learnmore']}}
产品信息
12119-1-AP
种属反应
宿主/亚型
分类
类型
抗原
偶联物
形式
浓度
规格
纯化类型
保存液
内含物
保存条件
运输条件
产品详细信息
Immunogen sequence: MAATVEGPE LEAAAAAGDA SEDSDAGSRA LPFLGGNRLS LDLYPGGCQQ LLHLCVQQPL QLLQVEFLRL STHEDPQLLE ATLAQLPQSL SCLRSLVLKG GQRRDTLGAC LRGALTNLPA GLSGLAHLAH LDLSFNSLET LPACVLQMRG LGALLLSHNC LSELPEALGA LPALTFLTVT HNRLQTLPPA LGALSTLQRL DLSQNLLDTL PPEIGGLGSL LELNLASNRL QSLPASLAGL RSLRLLVLHS NLLASVPADL ARLPLLTRLD LRDNQLRDLP PELLDAPFVR LQGNPLGEAS PDAPSSPVAA LIPEMPRLFL TSDLDSFPVT PRGCSVTLAC GVRLQFPAGA T (1-350 aa encoded by BC014904)
靶标信息
The protein encoded by this gene contains a leucine-rich repeat and a death domain. This protein has been shown to interact with other death domain proteins, such as Fas (TNFRSF6)-associated via death domain (FADD) and MAP-kinase activating death domain.
仅用于科研。不用于诊断过程。未经明确授权不得转售。
生物信息学
蛋白别名: DKFZp434D229; leucine-rich and death domain containing; Leucine-rich repeat and death domain-containing protein; leucine-rich repeats and death domain containing; MGC16925; p53 induced protein with a death domain; p53 protein induced, with death domain; p53-induced death domain-containing protein 1; p53-induced protein with a death domain; unnamed protein product
基因别名: 1200011D09Rik; AU042446; LRDD; MRT75; PIDD; PIDD1
UniProt ID: (Human) Q9HB75, (Mouse) Q9ERV7
Entrez Gene ID: (Human) 55367, (Mouse) 57913, (Rat) 293625